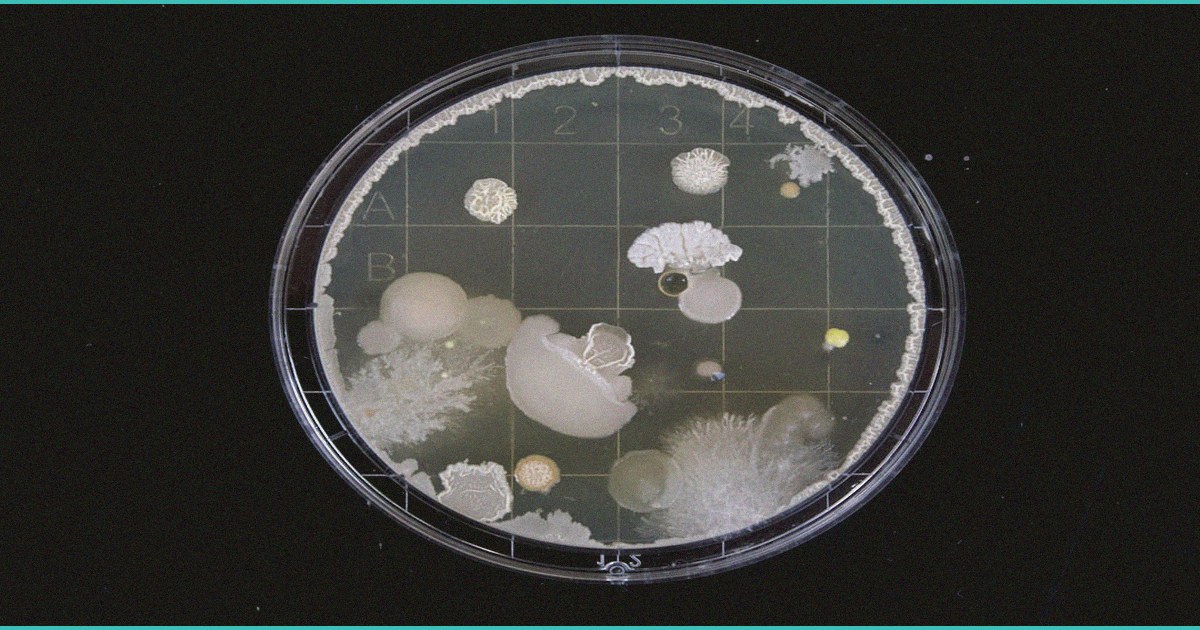
teen b marijuana b use doubles chances of futur

#78 Strong Clinical Relevance
High-quality evidence with meaningful patient or clinical significance.
Clinicians should understand this finding when assessing mental health risk in adolescent patients, as early cannabis use may be a modifiable risk factor for serious psychiatric outcomes that warrants preventive counseling. Patients with family histories of psychotic disorders face particularly elevated risk and may benefit from explicit guidance about avoiding cannabis during critical neurodevelopmental periods. This evidence supports integrating cannabis use screening and risk assessment into routine adolescent care and mental health evaluations.
A longitudinal study examining the relationship between adolescent cannabis use and psychiatric outcomes found that teenagers who use marijuana have approximately double the risk of developing psychotic disorders in adulthood compared to non-users, with risk appearing to increase with frequency and earlier age of initiation. The research tracked developmental trajectories from adolescence into early adulthood, controlling for baseline psychiatric symptoms and familial predisposition, suggesting a causal rather than merely correlational association between teen cannabis exposure and later psychosis. These findings carry significant clinical implications for patient counseling, particularly regarding the developing adolescent brain’s vulnerability to cannabis’s psychotomimetic effects and the potential for early intervention to prevent serious psychiatric morbidity. Clinicians should incorporate this evidence into discussions with adolescent patients and families about cannabis use, emphasizing that teenage exposure represents a distinct and elevated risk period compared to adult use. The study underscores the importance of screening for cannabis use during adolescent mental health evaluations and provides concrete epidemiological support for prevention messaging. Practitioners should counsel teenage patients that delaying cannabis initiation and avoiding regular use during this critical neurodevelopmental window may substantially reduce their lifetime risk of psychotic illness.
“We know from two decades of longitudinal research that adolescent cannabis use, particularly in those with genetic vulnerability, genuinely increases the risk of psychotic disorders in ways that adult use does not, and this should inform how we counsel families and how we think about prevention in younger populations.”
🧠 The association between adolescent cannabis use and subsequent psychotic disorders reported in this study adds to existing evidence suggesting developmental vulnerability during teen years, though clinicians should note that correlation does not establish causation and multiple confounders including genetic predisposition, concurrent substance use, and underlying psychiatric conditions may contribute to observed risk. The doubling of risk cited in headlines warrants contextualization within baseline prevalence rates, as absolute risk increase may be modest despite relative risk elevation. This research supports current clinical guidance that adolescents represent a particularly susceptible population, possibly due to ongoing brain maturation and prefrontal development, making screening for cannabis use and early psychotic symptoms especially relevant during teen health visits. When counseling families about cannabis, providers can cite this evidence alongside information about legal status, impaired driving, and academic impacts to support comprehensive prevention conversations. For clinicians evaluating teens with emerging psychotic symptoms, obtaining a detailed substance use history including cannabis frequency,
💬 Join the Conversation
Have a question about how this applies to your situation? Ask Dr. Caplan →
Want to discuss this topic with other patients and caregivers? Join the forum discussion →
FAQ
This News item was assembled from structured source metadata and pipeline scoring.
Have thoughts on this? Share it: